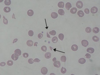

Njurdiagnostik och sjukdomar Flashcards
(59 cards)
Patofysiologi och diagnostik vid njursjukdom
- Utreda och behandla njursjukdomar
- Förebygga progress och komplikationer av njursvikt
- Hjälpa pat. leva utan egen njurfunktion – dialys
- Njurtransplantation
Nämn 6 funktioner som njure har
- Eliminera vattenlösliga slaggprodukter
- Reglera vätske- och saltbalansen
- Reglera blodtrycket
- Reglera syra/bas-balansen
- Reglering av Ca2+, fosfat och skelettmetabolism
- Styra bildning av erytrocyter
Vilken strategi har njuren övergripande?
- Producera stort ultrafiltrat, återvinna allt som är värt att spara och sedan låta det som blir kvar försvinna ur kroppen
Vilka basala mått ska vi ha koll på för njuren?
- RBF – 1,2-1,3 l/min (25 % av CO)
- GFR – 100 ml/min
- Sluturin 1-2ml/min
- Misstanke om njursjukdom (hematuri, proteinuri)
- Vid uppföljning och behandling av njursjukdom
- Vid uppföljning av sjukdom som kan skada njurarna (diabetes, hjärtsvikt, hypertoni)
- Inför behandling med mediciner som utsöndras via njurarna, (antibiotika, cytostatika, antiepileptiska)
- Vid vätskebalansrubbning (trauma, kräkningar, intorkning)
Vid någon av ovan så bör vi?
Göra test rörande GFR
Vad används i dagligt tal som synonym till njurfunktion?
Clearence
Hur ser vi sänkt funktion av clearance med ålder?
Minus 1 % per år efter 40 års ålder
Vilka nackdelar har kreatininclearence?
- Dygnsamlingar otillförlitligt (glömska osv)
- Krea inte bara GFR – tubulär sekretion 15 %, även viss resorption
- Varierande produktionshastighet (muskelmassa)
- Eftersom kreatinin bildas i jämn takt av all muskelvävnad
- Vid låg GFR (mindre än 10 ml/min) överskattas GFR vid kreatininclearance
- Viss elimination via tarm
Vilken exogen substans är bäst för att mäta clearance?
Iohexol
Hur mäter vi plasmaclearance (exogen substans) med iohexol
- Injicera iohexol (röntgenkontrastmedel), bra metod
- Ta blodprover vid definierade tidpunkter mellan 3 och 4h (efter intag), vid nedsatt njurfunktion vänta 24 h (tar tid)
- Mät koncentrationer
- Beräkna AUC (area under the curve)
- Beräkna clearance = GFR
- Vid logaritmering får vi rak linje

Markörsubstans (Kreatinin, Cystatin c, (urea))
- Krav på markörsubstans renal clearance
Ja, vad bör vi kräva att marören?
- Endogen och låg molekylär vikt
- Konstant bildningshastighet
- Elimination endast genom glomerulär filtration
- Stabilt i provrör
- Bra mätmetod
S-cystatin C
- Extracellulär proteashämmare
Vilka fördelar har denna clearencemarkör?
- Produceras med konstant hastighet
- Utsöndras bara via glomerulärfiltration
- Påverkas inte av inflammation
- Stabil i plasmarör
- Lika bra i alla åldrar
S-cystatin C
Extracellulär proteashämmare
Vilka nackdelar har denna clearencemarkör?
- Påverkas av graviditet och kortisonbehandling (pat. med reumatid artrit, astma osv)
- Tyroideasjukdomar
Vilken clearencemarkör kan vara lämplig om vi inte har tyroideasjukdomar och ej behandlar med kortison (inflammationssjukdomar som artrit etc)?
Cystatin C
- Slutprodukt i proteinnedbrytning
- Utsöndras genom glomerulär filtration
-
Ingen bra GFR-markör
- Betydande tubulär resorption
- Komplicerad metabolism
- Kostberoende
- Ökar vid katabolism och tarmblödning
Vad pratar vi om ovan?
P-urea
Varför använder vi inte alltid bara Iohexol som markör för clearence?
- Iohexol är dyrt, tidskrävande och vid nedsatt njurfunktion kan pat. behöva lämna prov dagen efter

Vad likställs vanligtvis proteinuri med?
Albuminuri
Vilka två typer av glomerulär proteinuri finns det?
Vad står de för?
-
Selektiv
- Kapillärväggens laddningsdensitet ökar den effektiva småporsstorleken
- Albumin passerar (ex vid minimal change nefropati)
-
Oselektiv
- Strukturell skada i kapillärväggen leder till ökat antal stora porer där flera proteiner passerar som albumin, IgM (ex vid membranös glomerulonefrit, diabetes)
- Högre risk för fibros och terminal uremi
Vad innebär tubulär proteinuri, vad släpps igenom och vad är prognosen?
- Problem med återresorptionsförmåga i proximala tubuli
- Protein HC (PHC) släpps igenom och återfinns i urin
- Vid glomerulär sjukdom och PHC hittas i urin tyder det på utveckling av tubulointerstitiell fibros, sämre prognos
Vad innebär överproduktionsproteinuri?
- Överproduktion av onormala proteiner pga sjukdom (t ex myelom, kappa- eller lambda light chains
-
Produktionen överskrider reabsorptionförmåga i proximala tubuli och återfinns därför i urin
- Bence Jones – myelom
- Lysozym – monocytär leukemi
- Myoglobin – rabdomyolys
- Hemoglobin - hemolys
Vad innebär funktionell proteinuri?
- Förändringar i renala plasmaflödet genom feber, fysisk ansträngning, stress
- Ej farligt, övergående
Vad innebär ortostatisk proteinuri?
- Ortostatisk (nämns bara snabbt)
- Ortostatisk proteinuri uppträder vid långvarig stående eller gått (“proteinuria en marche”) med snabb försvinnande i ett horisontellt läge. Mängden utsöndring av proteiner med urin överstiger inte 1 g / dag. Ortostatisk proteinuri är glomerulär och icke-selektiv och, enligt långvariga studier, är alltid godartad.
Analyser vid proteinuri
- Urinsticka; screening (semikvantitativ analys), EJ kvantitativ metod
- Dygnsurinsamling
- U-proteinprofil, mäta andra proteiner (lätta kedjor (Bence Jones) osv)
Nämn två andra metoder och vad som är viktigt att tänka?
- U-alb konc (stickprov)
- Dygnsmängd < 0,03 g/dygn
- U-alb/krea kvot (används ofta)
- Bra för att kvantifiera läckaget
- <3,0 g/mol (normalt morgonprov)
- Signifikant vid >30g/mol och njurbiopsi ska övervägas (>100g/mol definitivt)
- Skilj mellan normalvärdesgräns, indikationsgräns för njurbiopsi och nivå för symptom (nefros)
Nefrotiskt syndrom
- Diagnos vid
- Dygnsmängd U-alb > 3,5 g/dygn (U-alb/krea kvot > 300 g/mol)
Vad kan vi i övrigt se kliniskt hos dessa patienter utöver p-alb <30g/L?
Vad är viktigt att tänka på i förhållande till plasma-albumin?
- Har ofta ödem, hyperkolesterolemi
- Ökad trombosrisk vid p-alb <25g/L), detta är ett lågt värde
Vad är viktigt att tänka på innan njurbiopsi (kontraindikationer)?
- Okontrollerat blodtryck > 160/90
- Få ner blodtryck först
- Bödningsbenägenhet (trombocytopeni, warfarinbehandling)
- Kolla PK-NRK, APT-tid och trombocyter
- Singelnjure
- Undersök funktion
- Skrumpnjurar
- Pågående infektion
- Oförmåga att ligga still (stor risk för blödning)